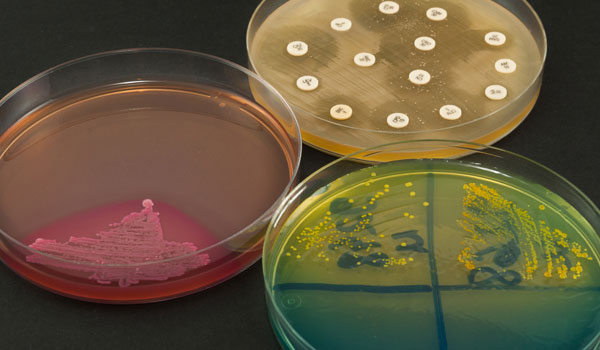
Bactériologie

Les examens de biologie effectués au sein de notre unité d’immunologie-sérologie infectieuse rendent un grand service dans l’exploration des désordres immunitaires (maladies auto-immunes, allergies, syndromes immuno-prolifératifs avec présence d’immunoglobuline monoclonale) ou contribuent au diagnostic des pathologies infectieuses (hépatites virales, toxoplasmose, syphilis…).
TDR-palu
AG HBS, AC HBC
Rubéole
Toxoplasmose
Chlamydia
CRP

Les analyses biochimiques sanguines sont des analyses de sang qui mesurent la quantité de certaines substances chimiques dans un prélèvement sanguin. Elles permettent d’évaluer la qualité de fonctionnement de certains organes et aussi de détecter des anomalies. Les analyses biochimiques sanguines peuvent aussi être appelées chimie du sang.
Calcium
Cholesterol total
Triglycerides
Urée
Creatinine
Hémoglobine glycosilée
Un examen ou analyse bactériologique permet de rechercher et d’identifier les bactéries en cause dans une infection.
Dépendamment du site de l’infection, plusieurs analyses sont possibles :
examens bactériologiques : des urines ou ECBU, des selles (voir coproculture),des sécrétions cervico-vaginales chez la femme, du sperme chez l’homme, des sécrétions bronchiques ou des crachats, etc...
ECBU simple
PCV
Spermogramme
Pus+ATB
Mycoplasme + ATB
Liquide de ponction+ATB

Les analyses effectuées au laboratoire d’hématologie consistent à évaluer les éléments qui composent le sang, la moelle osseuse et les liquides biologiques. L’analyse de la formule sanguine complète (FSC) est réalisée par un analyseur automatisé qui fournit des données, entre autres, sur les globules rouges, les globules blancs et les plaquettes.
NFS
Electrophorèse de l'hémoglobine
Temps de coagulation
Temps de saignement
Electrophorèse des protéines
D-Dimères

Les hormones sont des substances chimiques synthétisées par les glandes endocrines (thyroïde, hypophyse, etc.). En réponse à un signal donné (une déshydratation, un stress, etc.), ces glandes libèrent leurs sécrétions dans le sang, qui les transporte jusqu’à des organes cibles pour y stimuler ou inhiber une réponses spécifique (réabsorption d’eau par les reins, libération de sucre et augmentation de la pression artérielle, etc.).
B-HCG quantitatif
FSH
Testostérone
Progestérone
Prolactine
T4